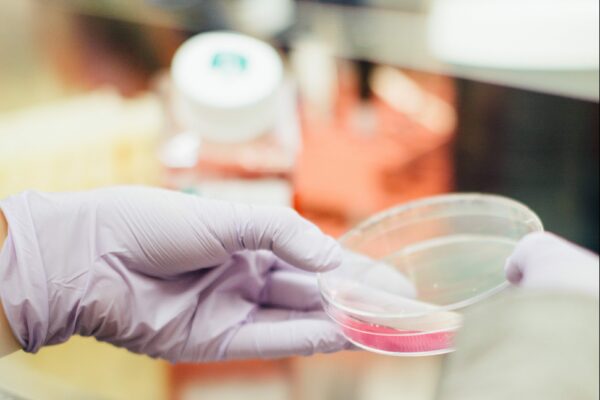

News
Synthetic route eliminates need for high potency equipment during manufacture of proprietary drug candidates Fort…
Provost & Chief Academic Officer of Howard University brings scientific experience and new perspectives on…
Adds extensive life science senior experience and transactional capability to the Board of Directors Fort…
Drug candidate active against EGFR and KRAS mutant lung cancer cell lines Fort Collins, CO,…
Novel Chemistry Allows Conjugation of Largazole Analogs to Receptor Ligands or Other Cytotoxic Agents Fort…
$1,000,000 NIH Grant will further development of Cetya’s HDAC inhibitor CT-101 for treatment of sickle…
$170,000 Colorado Grant will advance Cetya’s novel targeted HDAC inhibitor program.
$240,000 Grant will allow evaluation of Cetya’s HDAC inhibitors for treatment of sickle cell disease.
$220,000 Round includes Canadian firm InSynchrony Ventures Inc Proceeds will advance oncology drug development. Fort…
Publications
- Bowers, A.; West, N.; Taunton, J.; Schreiber, S. L.; Bradner, J. E.; and R. M. Williams, Total Synthesis and Biological Mode of Action of Largazole: A Potent Class I Histone Deacetylase Inhibitor. J Am Chem Soc. 2008, 130, 11219–22. >>
- Guerra-Bubb, J. M.; Bowers, A.; Smith, W. B.; Paranal, R.; Estiu, G.; Wiest, O.; Bradner, J. E.; and R. M. Williams, Synthesis and HDAC Inhibitory Activity of Isosteric Thiazoline-Oxazole Largazole Analogs. Bioorg. Med. Chem. Lett. 2013, 23, 6025–8. >>
- Bowers, A. A.; West, N.; Newkirk, T. L.; Troutman-youngman, A. E.; Schreiber, S. L.; Wiest, O.; Bradner, J. E.; and R. M. Williams, Synthesis and HDAC Inhibitory Activity of Largazole Analogs: Alteration of the Zinc-Binding Domain and Macrocyclic Scaffold. Org Lett. 2009, 11, 1301–1304. >>
- Bowers, A. A.; Greshock, T. J.; West, N.; Estiu, G.; Stuart, L.; Wiest, O.; Williams, R. M.; and J. E. Bradner, Synthesis and Conformation-Activity Relationships of the Peptide Isosteres of FK228 and Largazole. J Am Chem Soc. 2009, 131, 2900–2905. >>
- Pilon J.L., Clausen D.J., Hansen R.J., Lunghofer P.J., Charles B., Rose B.J., Thamm D.H., Gustafson D.L., Bradner J.E., Williams R.M. Comparative pharmacokinetic properties and antitumor activity of the marine HDACi largazole and largazole peptide isostere. Cancer Chemother. Pharmacol. 2015;75:671–682. doi: 10.1007/s00280-015-2675-1. >>
- Junker L.H., Li B., Zhu X., Koti S., Cerbone R.E., Hendrick C.L., Sangerman J., Perrine S., Pace B.S. Novel histone deacetylase inhibitor CT-101 induces γ-globin gene expression in sickle erythroid progenitors with targeted epigenetic effects. Blood Cells Mol. Dis. 2021; 93:102626. doi.org/10.1016/j.bcmd.2021.102626. >>
- Takezaki M., Li B., Xu H., Patel N., Lucas R., Cerbone R.E., Koti S., Hendrick C.L., Junker L.H., Pace B.S. The histone deacetylase inhibitor CT-101 flips the switch to fetal hemoglobin expression in sickle cell disease mice. PLoS One 2025 doi.org/10.1371/journal.pone.0323550. >>